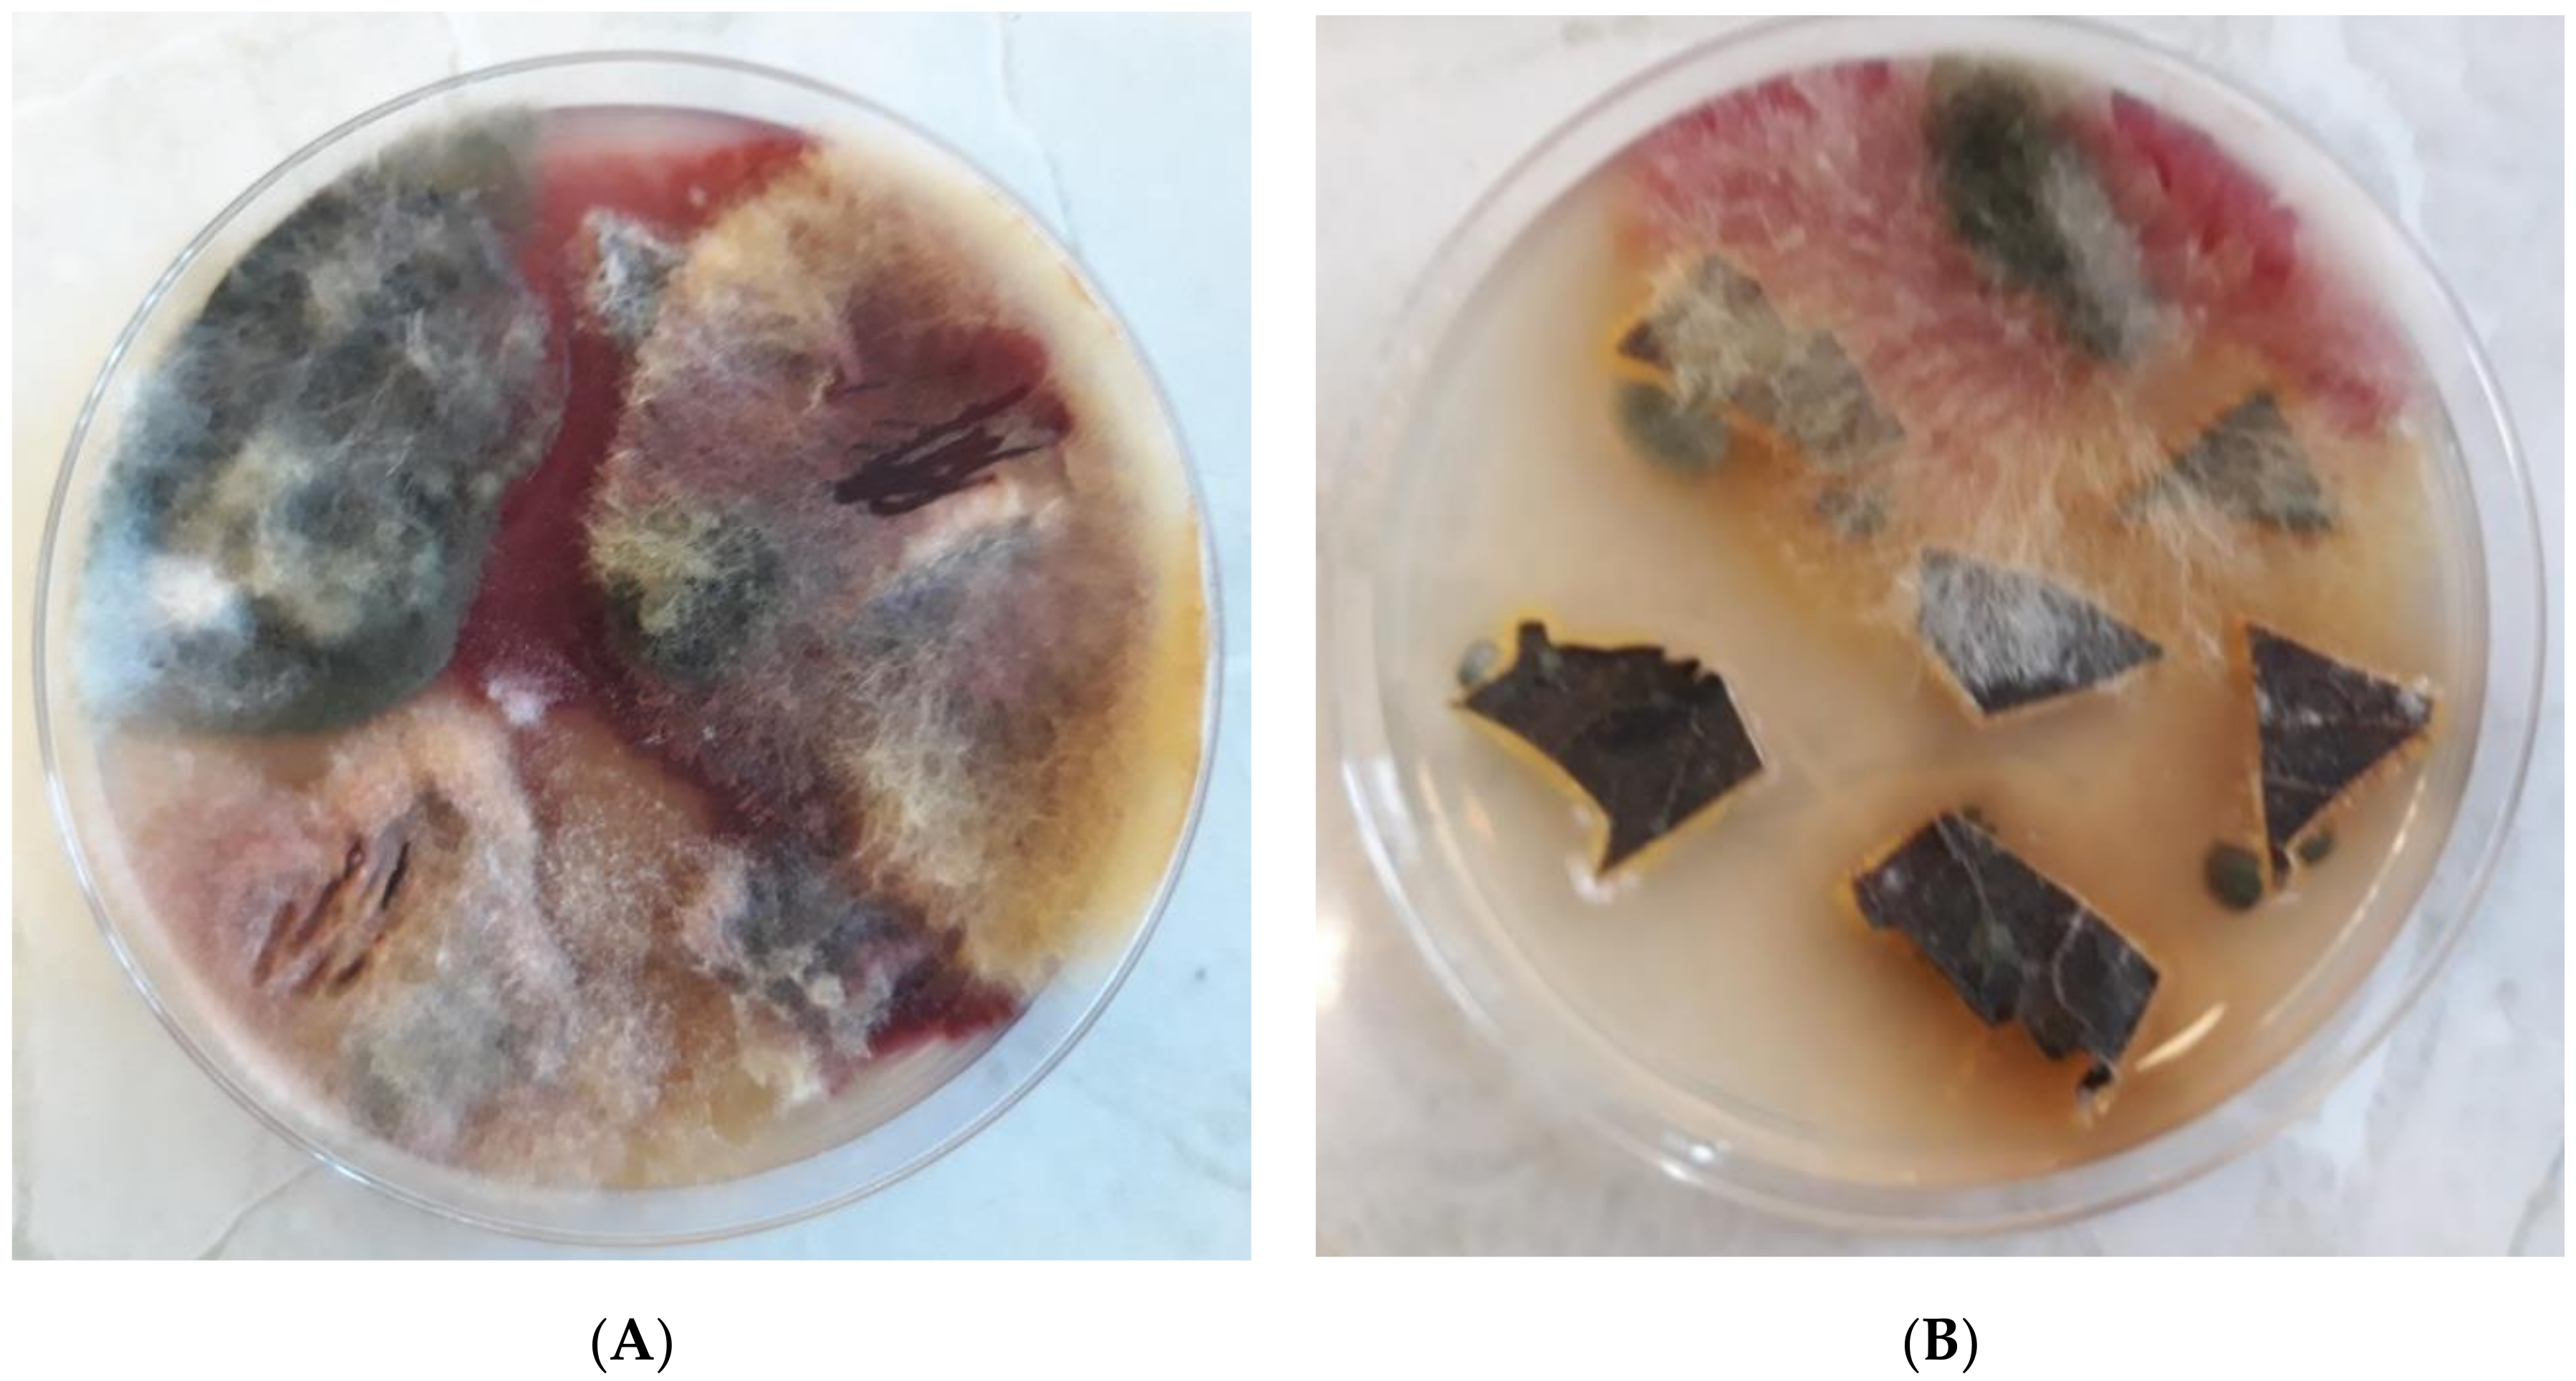
Agronomy 11 00234 g008 Agronomy 11 00234 g008
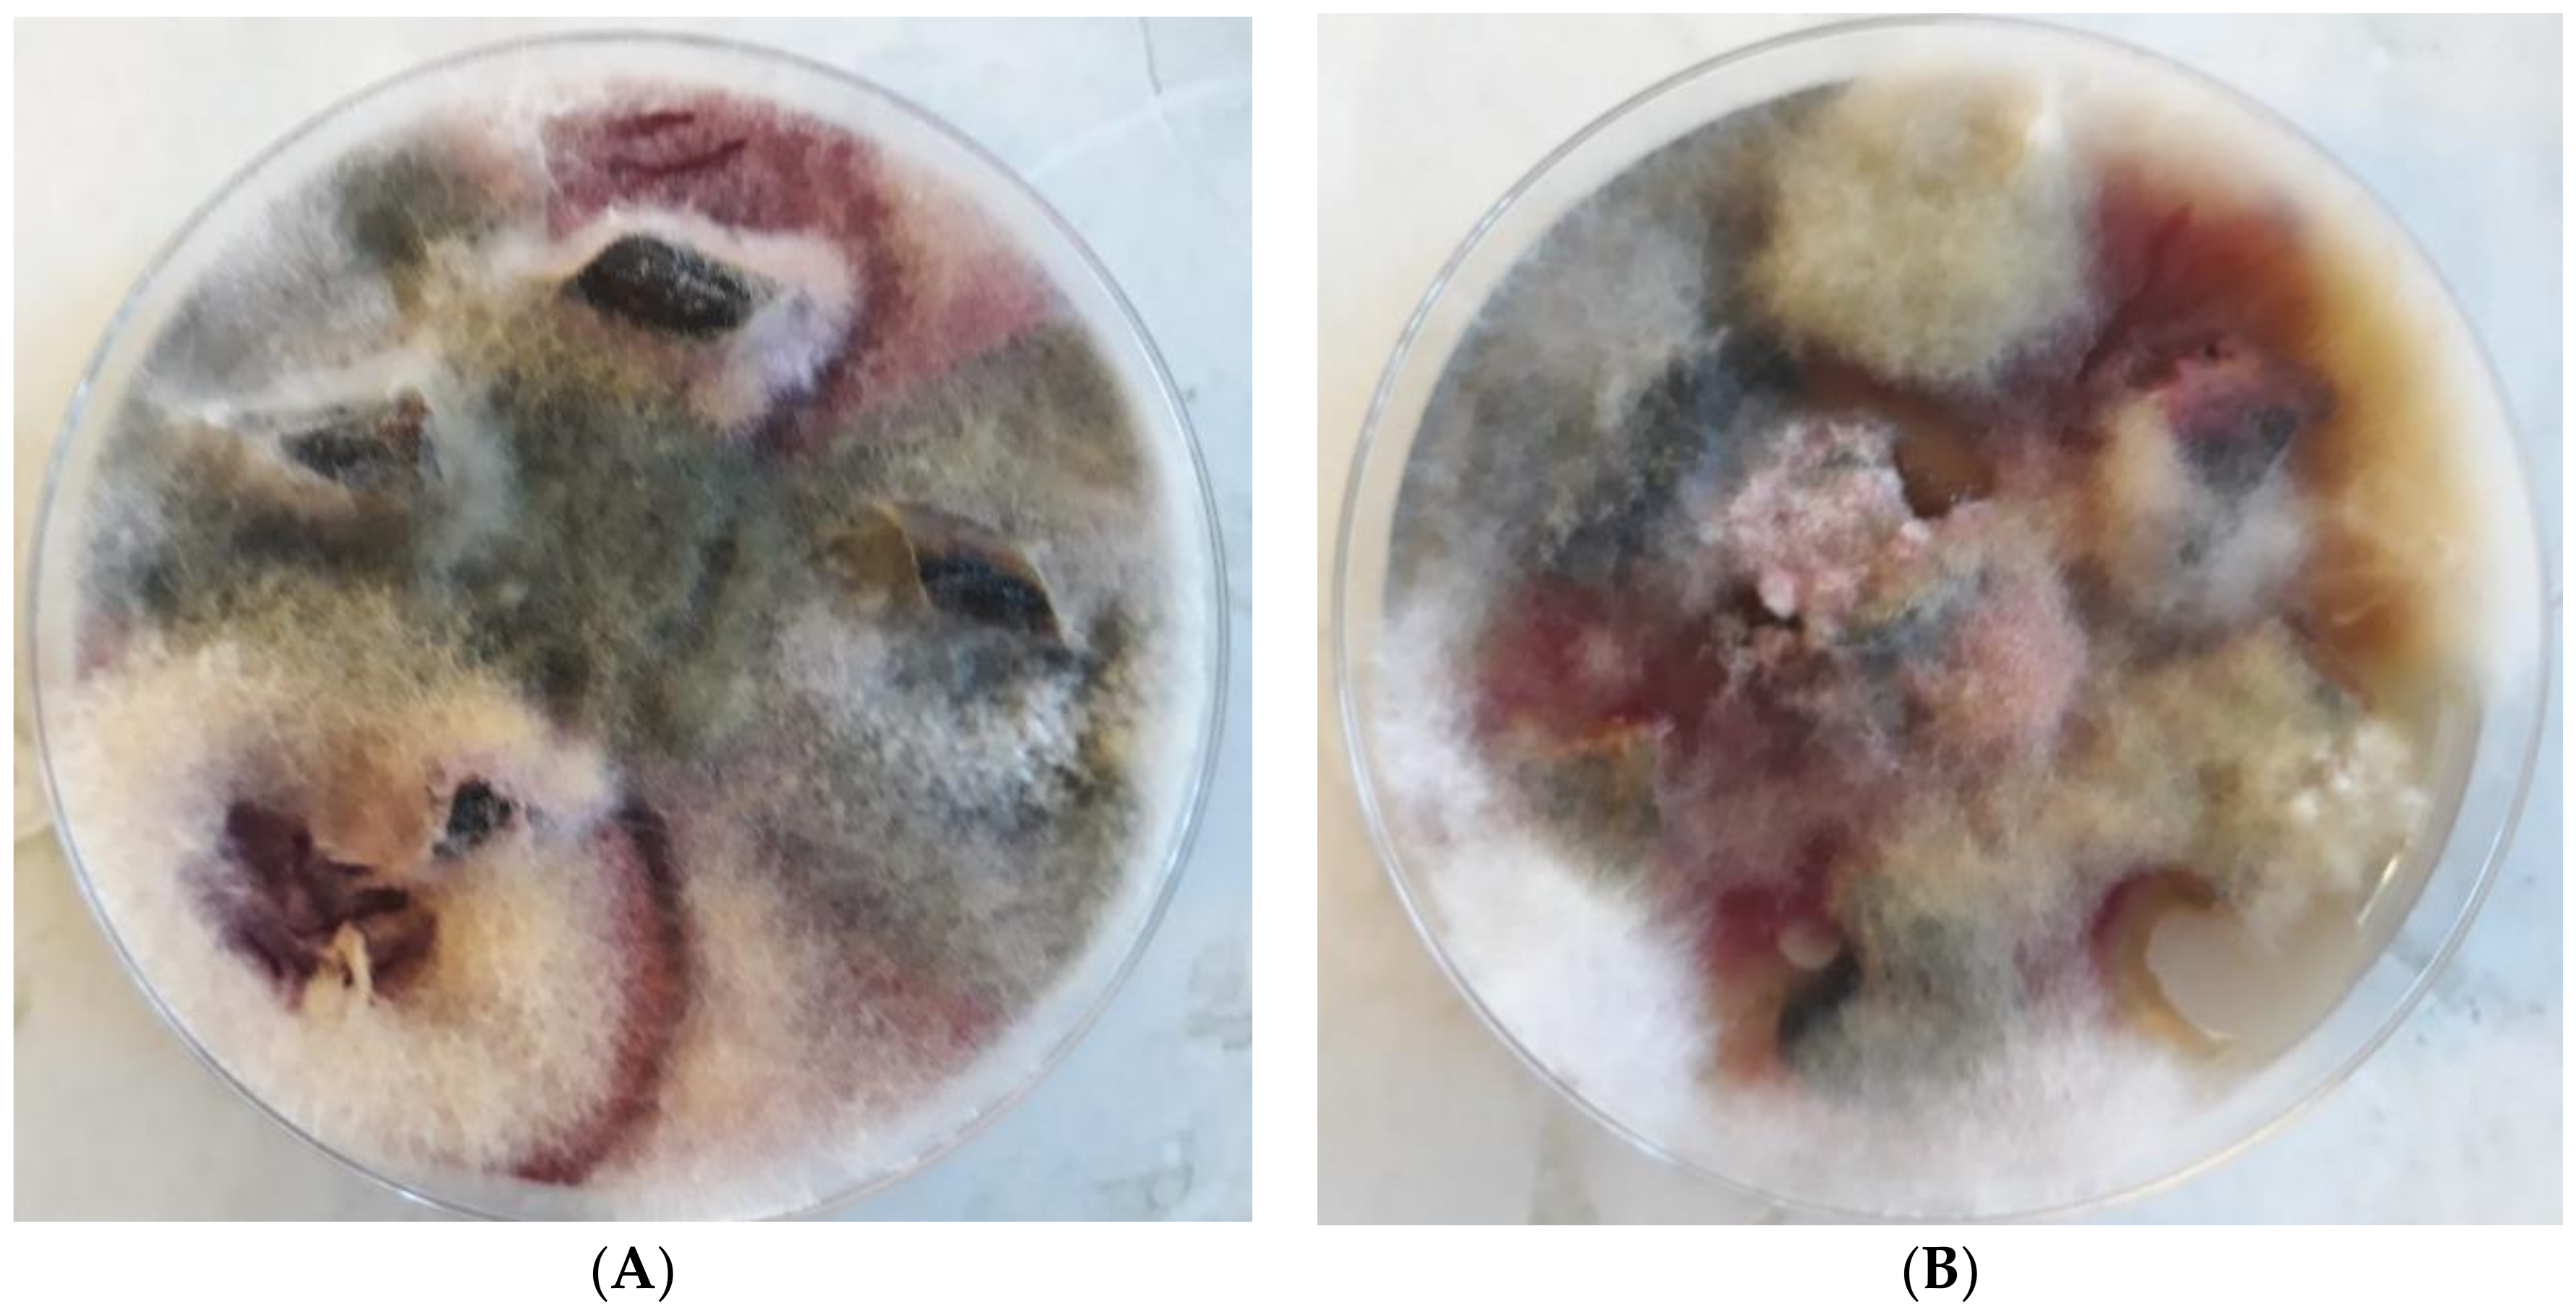
Agronomy 11 00234 g010 Agronomy 11 00234 g010

The Effects of Potassium Fertilization and Irrigation on the Yield and Health Status of Jerusalem Artichoke (Helianthus tuberosus L.)
Abstract
1. Introduction
2. Materials and Methods
2.1. Field Experiment
2.2. Mycological Analyses of Jerusalem Artichoke Leaves and Tubers
2.3. Analysis of Pathogenic and Saprotrophic Fungi
2.4. Weather Conditions
2.5. Statistical Analysis
3. Results and Discussion
3.1. Total Tuber Yields and Above-Ground Biomass Yields
3.2. Mycological Analyses of Tubers and Aerial Plant Parts
4. Conclusions
Supplementary Materials
Author Contributions
Funding
Institutional Review Board Statement
Informed Consent Statement
Acknowledgments
Conflicts of Interest
References
- Praznik, W.; Cieślik, E.; Filipiak-Florkiewicza, A. Soluble dietary fibres in Jerusalem artichoke powders: Composition and application in bread. Nahrung/Food 2002, 46, 151–157. [Google Scholar] [CrossRef]
- Panchev, I.; Delchev, N.; Kovacheva, D.; Slavov, A. Physicochemical characteristics of inulins obtained from Jerusalem artichoke (Helianthus tuberosus L.). Eur. Food Res. Technol. 2011, 233, 889–896. [Google Scholar] [CrossRef]
- Yang, L.; He, Q.S.; Corscadden, K.; Udenigwe, C.C. The prospects of Jerusalem artichoke in functional food ingredients and bioenergy production. Biotechnol. Rep. 2015, 5, 77–88. [Google Scholar] [CrossRef]
- Lakíc, Ž.; Balalíc, I.; Nožiníc, M. Genetic variability for yield and yield components in jerusalem artichoke (Helianthus tuberosus L.). Genetika 2018, 50, 45–57. [Google Scholar] [CrossRef]
- Pan, L.; Sinden, M.R.; Kennedy, A.H.; Chai, H.; Watson, L.E.; Graham, T.L.; Kinghorn, A.D. Bioactive constituents of Helianthus tuberosus (Jerusalem artichoke). Phytochem. Lett. 2009, 2, 15–18. [Google Scholar] [CrossRef]
- Yuan, X.; Gao, M.; Xiao, H.; Tan, C.; Du, Y. Free radical scavenging activities and bioactive substances of Jerusalem artichoke (Helianthus tuberosus L.) Leaves. Food Chem. 2012, 133, 10–14. [Google Scholar] [CrossRef]
- Sawicka, B.; Skiba, D.; Pszczółkowski, P.; Aslan, I.; Sharifi-Rad, J.; Krochmal-Marczak, B. Jerusalem artichoke (Helianthus tuberosus L.) As a medicinal plant and its natural products. Cell. Mol. Biol. 2020, 66, 161–178. [Google Scholar] [CrossRef]
- Soja, G.; Dersch, G.; Praznik, W.I. Harvest dates, fertilizer and varietal effects on yield, concentration and molecular distribution of fructan in Jerusalem artichoke (Helianfhus tuberosus L.). J. Agron. Crop Sci. 1990, 165, 181–189. [Google Scholar] [CrossRef]
- Swanton, C.J.; Cavers, P.B.; Clementsl, D.R.; Mooret, M.J. The biolory of Canadian weeds. 101. Helianthus tuberosusl. Can. J. Plant Sci. 1992, 72, 1367–1382. [Google Scholar] [CrossRef]
- Matias, J.; Gonzales, J.; Cabanillas, J.; Royano, L. Influence of NPK fertilisation and harvest date on agronomic performance of Jerusalem artichoke crop in the Guadiana Basin (Southwestern Spain). Ind. Crop. Prod. 2013, 48, 191–197. [Google Scholar] [CrossRef]
- Ruttanaprasert, R.; Banterng, P.; Jogloy, S.; Vorasoot, N.; Kesmala, T.; Kanwar, R.S.; Holbrook, C.C.; Patanothai, A. Genotypic variability for tuber yield, biomass, and drought tolerance in Jerusalem artichoke germplasm. Turk. J. Agric. For. 2014, 38, 570–580. [Google Scholar] [CrossRef]
- Stolarski, M.J.; Krzyżaniak, M.; Warmínski, K.; Tworkowski, J.; Szczukowski, S.; Olba-Zįety, E.; Gołaszewski, J. Energy efficiency of herbaceous crops production depending on the type of digestate and mineral fertilizers. Energy 2017, 134, 50–60. [Google Scholar] [CrossRef]
- Paixão, S.M.; Alves, L.; Pacheco, R.; Silva, C.M. Evaluation of Jerusalem artichoke as a sustainable energy crop to bioethanol: Energy and CO2eq emissions modeling for an industrial scenario. Energy 2018, 150, 468–481. [Google Scholar] [CrossRef]
- Rossini, F.; Provenzano, M.E.; Kuzmanovíc, L.; Ruggeri, R. Jerusalem Artichoke (Helianthus tuberosus L.): A Versatile and Sustainable Crop for Renewable Energy Production in Europe. Agronomy 2019, 9, 528. [Google Scholar] [CrossRef]
- Sawicka, B.; Skiba, D.; Bienia, B.; Kieltyka-Dadasiewicz, A.; Danilcenko, H. Jerusalem artichoke (Helianthus tuberosus L.) As energy raw material. In Proceedings of the 9th International Scientific Conference Rural Development, Research and Innovation for Bioeconomy, Kaunas, Lithuania, 26–28 September 2019; pp. 336–342. [Google Scholar] [CrossRef]
- Denoroy, P. The crop physiology of Helianthus tuberosus L.: A model orientated view. Biomass Bioenerg. 1996, 11, 11–32. [Google Scholar] [CrossRef]
- Paolini, R.; Del Puglia, S.; Abbate, V.; Copani, V.; Danuso, F.; De Mastro, G.; Losavio, N.; Marzi, V.; Molfetta, P.; Pignatelli, V.; et al. Produttività del topinambur (Helianthus tuberosus L.) in relazione a fattori agronomici diversi. Agric. Ric. 1996, 163, 126–144. [Google Scholar]
- Danuso, F. Le colture per la produzione di inulina: Attualità eprospettive. Riv. Agron. 2001, 35, 176–187. [Google Scholar]
- Izsáki, Z.; Kádi, G.N. Biomass acumulation and nutrient uptake of Jerusalem artichoke (Helianthus tuberosus L.). Am. J. Plant Sci. 2013, 4, 1629–1640. [Google Scholar] [CrossRef]
- Gao, K.; Zhang, Z.; Zhu, T.; Coulter, J.A. The influence of flower removal on tuber yield and biomass characteristics of Helianthus tuberosus L. in a semi-arid area. Ind. Crop. Prod. 2020, 150, 112374. [Google Scholar] [CrossRef]
- Soja, G.; Haunold, E. Leaf gas exchange and tuber yield in Jerusalem artichoke (Helianthus tuberosus L.) Cultivars. Field Crop Res. 1991, 26, 241–252. [Google Scholar] [CrossRef]
- Westermann, D.T.; James, D.W.; Tindall, T.A.; Hurst, R.L. Nitrogen and potassium fertilization of potatoes: Sugars and starch. Am. Potato J. 1994, 71, 433–453. [Google Scholar] [CrossRef]
- Monti, A.; Amaducci, M.T.; Venturi, G. Growth response, leaf gas exchange and fructans accumulation of Jerusalem artichoke (Helianthus tuberosus L.) As affected by different water regimes. Eur. J. Agron. 2005, 23, 136–145. [Google Scholar] [CrossRef]
- Long, X.H.; Mehta, S.K.; Liu, Z.P. Efect of NO−3-N enrichment on seawater stress tolerance of jerusalem artichoke (Helianthus tuberosus). Pedosphere 2008, 18, 113–123. [Google Scholar] [CrossRef]
- Kays, S.J.; Nottingham, S.F. Biology and Chemistry of Jerusalem Artichoke: Helianthus tuberosus L.; CRC Press; Taylor & Francis Group: London, UK, 2008; ISBN 9781420044959. [Google Scholar]
- Koike, S.T. Southern blight of Jerusalem artichoke caused by Sclerotium rolfsii. in California. Plant Dis. 2004, 88, 769. [Google Scholar] [CrossRef]
- Sennoi, R.; Jogloy, S.; Saksirirat, W.; Patanothai, A. Pathogenicity test of Sclerotium rolfsii, a causal agent of Jerusalem artichoke (Helianthus tuberosus L.) stem rot. Asian J. Plant Sci. 2010, 95, 281–284. [Google Scholar] [CrossRef]
- Labergh, C.; Sackston, W.E. Adaptability and diseases of Jerusalem artichoke (Helianthus tuberosus) in Quebec. Can. J. Plant Sci. 1987, 67, 349–353. [Google Scholar] [CrossRef]
- Dudhe, M.Y.; Bharsakle, S.S. Screening of germplasm line for resistance to Alterneria blight and necrosis disease in sunflower. Crop Prot. Prod. 2005, 1, 84–87. [Google Scholar]
- Viriyasuthee, V.; Jogloy, S.; Saksirirat, W.; Saepaisan, S.; Gleason, M.L.; Chen, R.S. Biological Control of Alternaria Leaf Spot Caused by Alternaria spp. in Jerusalem Artichoke (Helianthus tuberosus L.) under Two Fertilization Regimes. Plants 2019, 8, 463. [Google Scholar] [CrossRef]
- Zhao, Y.-Q.; Zhang, D.M.; Zhang, L.J.; Yu, X.Y.; Yu, H.R.; Shi, K.; Gao, K. First Report of Brown Spot on Jerusalem Artichoke (Helianthus tuberosus) Caused by Bipolaris zeae in China. Plant Dis. 2017, 101, 2146. [Google Scholar] [CrossRef]
- Kosaric, N.; Cosentino, G.P.; Wieczorek, A.; Duvnjak, Z. The Jerusalem artichoke as an agricultural crop. Biomass 1984, 5, 1–36. [Google Scholar] [CrossRef]
- AbdAl-Aziz, S.A.A.; El-Metwally, M.M.; Saber, I.A. Molecular identification of a novel inulinolytic fungus isolated from and grown on tubers of Helianthus tuberosus and statistical screening of medium components. World J. Microb. Biot. 2012, 28, 3245–3254. [Google Scholar] [CrossRef]
- Stolzenburg, K. Anbau und Verwertung von Topinambur (Helianthus tuberosus L.). Inf. furPflanzenproduktion Sonderh. 2002, 1, 1. [Google Scholar]
- PIORiN. Integrated Production Method for Potatoes. Main Inspectorate of Plant Health and Seed Inspection. 2014. Available online: http://www.piorin.gov.pl/30.01.2020 (accessed on 15 June 2020). (In Polish)
- IUSS Working Group WRB. World Reference Base for Soil Resources. In World Soil Resources Reports, 2nd ed.; FAO: Roma, Italy, 2006. [Google Scholar]
- Houba, V.J.G.; Van der Lee, J.J.; Novozamsky, I. Soil and Plant Analysis. Part 5B. In Soil Analysis Procedure Other Procedure; Wageningen Agriculture University: Wageningen, The Netherlands, 1995. [Google Scholar]
- Ellis, M.B. Dematiaceous Hyphomycetes; Commonwealth Mycological Institute Kew: Surrey, UK, 1971. [Google Scholar]
- Leslie, J.F.; Summerell, B.A. The Fusarium Laboratory Manual; Blackwell Publishing: Ames, IA, USA, 2006. [Google Scholar] [CrossRef]
- Watanabe, T. Pictorial, Atlas of Soil and Seed Fungi. In Morphologies of Cultured Fungi and Key to Species, 2nd ed.; CRC Press: Boca Raton, FL, USA, 2002; p. 504. ISBN 9781439804193. [Google Scholar]
- Du, W.; Yao, Z.; Li, J.; Sun, C.; Xia, J.; Wang, B.; Shi, D.; Ren, L. Diversity and antimicrobial activity of endophytic fungi isolated from Securinega suffruticosa in the Yellow River Delta. PLoS ONE 2020, 10, e0229589. [Google Scholar] [CrossRef]
- Bac, S.; Koźmiński, C.; Rojek, M. Agrometeorologia (Agrometeorology); Polish Scientific Publishers PWN: Warsaw, Polish, 1998. (In Polish) [Google Scholar]
- Statsoft Inc. Statistica (Data Analysis Software System), 10th ed.; Statsoft Inc.: Tulsa, OK, USA, 2011; Available online: http:/www.statsoft.com (accessed on 1 April 2020).
- Rodrigues, M.A.; Sousa, L.; Cabanas, J.E.; Arrobas, M. Tuber yield and leaf mineral composition of Jerusalem artichoke (Helianthus tuberosus L.) Grown under different cropping practices. Span. J. Agric. Res. 2007, 5, 545–553. [Google Scholar] [CrossRef][Green Version]
- Conde, J.R.; Lenorio, J.L.; Rodríguez-Maribona, B.; Ayerbet, L. Tuber yield of Jerusalem artichoke (Helianthus tuberosus L.) in relation to water stress. Biomass Bioenerg. 1991, 1, 137–142. [Google Scholar] [CrossRef]
- Baldini, M.; Danuso, F.; Monti, A.; Amaducci, M.T.; Stevanato, P.; Mastro, G. Chichory and Jerusalem artichoke productivity in different areas of Italy, in relation to water availability and time of harvest. Ital. J. Agron. Riv. Agron. 2006, 2, 291–307. [Google Scholar] [CrossRef]
- Kim, S.; Kim, C.H. Evaluation of whole Jerusalem artichoke (Helianthus tuberosus L.) For consolidated bioprocessing ethanol production. Renew. Energ. 2014, 65, 83–91. [Google Scholar] [CrossRef]
- Pimsaen, W.; Jogloy, S.; Suriharn, B.; Kesmala, T.; Pensuk, V.; Patanothai, A. Genotype by Environment (GxE) Interactions for Yield Components of Jerusalem Artichoke (Helianthus tuberosus L.). Asian J. Plant Sci. 2010, 9, 11–19. [Google Scholar] [CrossRef][Green Version]
- Raso, E. Jerusalem Artichoke. Effect of Nitrogen-Potassium Fertilizing. Terra e Sole 1990, 45, 431–433. [Google Scholar]
- Schittenhelm, S. Agronomic Performance of Root Chicory, Jerusalem Artichoke, and Sugarbeet in Stress and Nonstress Environments. Crop Sci. 1999, 39, 1815–1823. [Google Scholar] [CrossRef]
- Gao, K.; Zhu, T.; Wang, Q. Nitrogen fertilization, irrigation, and harvest times affect biomass and energy value of Helianthus tuberosus L. J. Plant Nutr. 2016, 39, 1906–1914. [Google Scholar] [CrossRef]
- Gunnarsson, I.B.; Svensson, S.E.; Johansson, E.; Karakashev, D.; Angelidaki, I. Potential of Jerusalem artichoke (Helianthus tuberosus L.) as a biorefinery crop. Ind. Crop. Prod. 2014, 56, 231–240. [Google Scholar] [CrossRef]
- Niu, L.; Manxia, C.; Xiumei, G.; Xiaohua, L.; Hongbo, S.; Zhaopu, L.; Zed, R. Carbon sequestration and Jerusalem artichoke biomass under nitrogen applications in coastal saline zone in the northern region of Jiangsu, China. Sci. Total Environ. 2016, 568, 885–890. [Google Scholar] [CrossRef]
- Viriyasuthee, W.; Saksirirat, W.; Saepaisan, S.; Gleason, M.L. Variability of Alternaria Leaf Spot Resistance in Jerusalem Artichoke (Helianthus tuberosus L.) Accessions Grown in a Humid Tropical Region. Agronomy 2019, 9, 268. [Google Scholar] [CrossRef]
- Lagopodi, A.L.; Thanassoulopoulos, C.C. Effect of a leaf spot disease caused by Alternaria alternata on yield of sunflower in Greece. Plant Dis. 1998, 82, 41–44. [Google Scholar] [CrossRef]
- Kgatle, M.G.; Flett, B.; Truter, M.; Ramusi, M.; Aveling, T. Distribution of Alternaria leaf blight of sunflowers caused by Alternaria alternata in South Africa. J. Agric. Rural Dev. Tropics Subtropics 2019, 120, 71–77. [Google Scholar] [CrossRef]
- Kgatle, M.G.; Flett, B.; Truter, M.; Aveling, T.A.S. Control of Alternaria leaf blight caused by Alternaria alternata on sunflower using fungicides and Bacillus amyloliquefaciens. Crop Prot. 2020, 132, 105146. [Google Scholar] [CrossRef]
- Cho, H.S.; Yu, S.H. Three Alternaria species pathogenic to sunflower. Plant Pathol. J. 2000, 16, 331–334. [Google Scholar]
- Prasad, M.S.L.; Sujatha, M.; Rao, S.C. Analysis of cultural and genetic diversity in Alternaria helianthi and determination of pathogenic variability using wild Helianthi species. J. Phytopathol. 2009, 157, 609–617. [Google Scholar] [CrossRef]
- Maldaner, I.C.; Heldwein, A.B.; Bortoluzzi, M.P.; Loose, L.H.; Lucas, D.D.P.; da Silva, J.R. Irrigation and fungicide application on disease occurrence and yield of early and late sown sunflower. Rev. Bras. Eng. Agric. Amb. 2015, 19, 630–635. [Google Scholar] [CrossRef]
- Wright, P.R. Research into early senescence syndrome in cotton. Better Crops Int. 1998, 12, 14–16. [Google Scholar]
- Blachinski, D.; Shtienberg, D.; Dinoor, A.; Kafkafi, U.; Sujkowski, L.S.; Zitter, T.A.; Fry, W.E. Influence of foliar application of nitrogen and potassium on Alternaria diseases in potato, tomato and cotton. Phytoparasitica 1996, 24, 281–292. [Google Scholar] [CrossRef]
- Jansopa, C.; Jogloy, S.; Saksirirat, W. Inoculation with Sclerotium rolfsii, cause of stem rot in Jerusalem artichoke, under field conditions. Eur. J. Plant Pathol. 2016, 146, 47–58. [Google Scholar] [CrossRef]
- Awad, A.A.M.; Ahmed, H.M.H. Impact of Organic Manure Combinations on Performance and Rot Infection of Stressed-Jerusalem Artichoke Plants. Egypt. J. Soil Sci. 2018, 58, 417–433. [Google Scholar] [CrossRef]
- Snowden, A.L. A Colour Allas of Post-Harvest Diseases and Disorders of Fruits and Vegetables: Vegetables; Manson Publishing CRC Press: Boca Raton, FL, USA, 2010; Volume 2, p. 416. [Google Scholar]
- Ezzat, A.E.S.; Ghoneem, K.M.; Saber, W.I.A.; Al-Askar, A.A. Control of wilt, stalk and tuber rots diseases using arbuscular mycorrhizal fungi, Trichoderma species and hydroquinone enhances yield quality and storability of Jerusalem artichoke (Helianthus tuberosus L.). Egypt. J. Biol. Pest Control 2015, 25, 11–22. [Google Scholar]
- Ghoneem, K.M.; Saber, W.I.A.; El-Awady, A.A.; Rashad, Y.M.; Al-Askar, A.A. Alternative preservation method against Sclerotium tuber rot of Jerusalem artichoke using natural essential oils. Phytoparasitica 2016, 44, 341–352. [Google Scholar] [CrossRef]
- Yang, S.P.; Du, G.L.; Tian, J.; Jiang, X.T.; Sun, X.M.; Li, Y.; Li, J.; Zhong, Q. First Report of Tuber Soft Rot of Jerusalem Artichoke (Helianthus tuberosus) Caused by Rhizopus arrhizus in Qinghai Province of China. Plant Dis. 2020, 104, 3265. [Google Scholar] [CrossRef]
- Doehlemann, G.; Ökmen, B.; Zhu, W.; Sharon, A. Plant pathogenic fungi. Microbiol. Spectr. 2016, 5, FUNK-0023-2016. [Google Scholar] [CrossRef]
- Sennoi, R.; Jogloy, S.; Saksirirat, W.; Kesmala, T.; Patanothai, A. Genotypic variation of resistance to southern stem rot of Jerusalem artichoke caused by Sclerotium rolfsii. Euphytica 2013, 190, 415–424. [Google Scholar] [CrossRef]

| Specification | Month | |||||||
|---|---|---|---|---|---|---|---|---|
| April | May | June | July | August | September | October | November | |
| Mean air temperature (°C) | 10.8 | 15.7 | 17.2 | 19.7 | 19.2 | 14.5 | 8.7 | 3.3 |
| 30-yr mean | 7.7 | 13.5 | 16.1 | 18.7 | 17.9 | 12.8 | 8.0 | 2.9 |
| Total rainfall (mm) | 33.5 | 25.0 | 53.7 | 141.0 | 44.6 | 20.3 | 84.7 | 16.0 |
| 30-yr mean | 33.3 | 58.5 | 80.4 | 74.2 | 59.4 | 56.9 | 42.6 | 44.8 |
| Water requirements of late-maturing potato varieties [35] | - | 62 | 74 | 97 | 79 | 50 | - | - |
| Selyaninov’s hydrothermal coefficient (K) * [41,42] | 1.03 | 0.51 | 1.04 | 2.30 | 0.75 | 0.47 | 3.14 | 1.61 |
| Parameter | Cv | K | Irrigation (IR) | Cv × K | Cv × IR | K × IR | Cv × K × IR |
|---|---|---|---|---|---|---|---|
| Total tuber yield (FM Mg ha−1) | 9.826 *** | 2.696ns | 59.120 *** | 3.105 ** | 0.601ns | 3.313 ** | 1.112ns |
| Total tuber yield (DM Mg ha−1) | 14.880 *** | 2.244ns | 50.849 *** | 3.271 ** | 0.677ns | 3.644 ** | 0.986ns |
| Above-ground biomass yield (FM Mg ha−1) | 10.896 *** | 7.714 ** | 77.245 *** | 6.702 *** | 1.403ns | 3.504 ** | 2.137ns |
| Above-ground biomass yield (DM Mg ha−1) | 8.051 *** | 5.051 ** | 54.275 *** | 4.158 *** | 0.799ns | 2.098ns | 1.498ns |
| Parameter | Total Tuber Yield FM | Total Tuber Yield DM | Above-Ground Biomass Yield FM | Above-Ground Biomass Yield DM |
|---|---|---|---|---|
| Cultivar | ||||
| Violette de Rennes | 43.17 b | 8.84 b | 55.97 b | 20.69 b |
| Waldspindel | 46.95 b | 12.23 a | 53.39 b | 19.59 b |
| Topstar | 60.53 a | 14.18 a | 65.74 a | 24.42 a |
| Potassium fertilizer (kg K2O ha−1) | ||||
| 150 | 55.73 a | 12.77 a | 64.40 a | 23.82 a |
| 250 | 47.36 a | 11.81 a | 53.70 b | 19.97 b |
| 350 | 47.55 a | 10.67 a | 57.00 b | 20.93 ab |
| Irrigation | ||||
| Irrigated | 63.14 a | 14.64 a | 68.38 a | 25.36 a |
| Not irrigated | 37.29 b | 8.86 b | 48.35 b | 17.78 b |
| Fungal Genus/Species | Irrigated | Total | Not Irrigated | Total | ||||||||||||||||
|---|---|---|---|---|---|---|---|---|---|---|---|---|---|---|---|---|---|---|---|---|
| Topstar | Waldspindel | Violette de Rennes | Top Star | Waldspindel | Violette de Rennes | |||||||||||||||
| Number of fungal isolates | ||||||||||||||||||||
| 150 * | 250 | 350 | 150 | 250 | 350 | 150 | 250 | 350 | ∑ | 150 | 250 | 350 | 150 | 250 | 350 | 150 | 250 | 350 | ∑ | |
| Alternaria alternata (Fr.) Keissl. | 9 | 13 | 16 | 12 | 15 | 14 | 8 | 13 | 11 | 111 | 14 | 14 | 19 | 10 | 9 | 7 | 12 | 22 | 13 | 120 |
| Alternaria spp. | 3 | 2 | 1 | 1 | 4 | 2 | 13 | 2 | 5 | 3 | 1 | 1 | 4 | 16 | ||||||
| Botrytis cinerea Pers. | 0 | 1 | 1 | |||||||||||||||||
| Chaetomium spp. | 0 | 1 | 1 | |||||||||||||||||
| Cladosporium cladosporioides (Fresen.) G.A. de Vries | 2 | 1 | 1 | 4 | 2 | 1 | 4 | 7 | ||||||||||||
| Epicoccum nigrum Link | 3 | 3 | 1 | 1 | 5 | 3 | 2 | 18 | 4 | 2 | 2 | 4 | 1 | 2 | 15 | |||||
| Fusarium avenaceum (Fr.) Sacc. | 1 | 1 | 1 | 1 | 1 | 5 | 1 | 3 | 3 | 4 | 11 | |||||||||
| Fusarium culmorum (Wm. G. SM.) Sacc. | 2 | 2 | 1 | 2 | 1 | 4 | ||||||||||||||
| Fusarium equiseti (Corda) Sacc. | 1 | 1 | 0 | |||||||||||||||||
| Fusarium poae (Pack) Wollenw. | 1 | 1 | 2 | 0 | ||||||||||||||||
| Fusarium tricinctum (Corda) Sacc. | 1 | 1 | 0 | |||||||||||||||||
| Fusarium sporitrichioides Scherb. | 0 | 1 | 2 | 1 | 6 | 1 | 11 | |||||||||||||
| Fusarium spp. | 1 | 1 | 1 | 3 | 0 | |||||||||||||||
| Mucor spp. | 1 | 1 | 0 | |||||||||||||||||
| Nigrpospora sphaerica (Sacc.) E.W. Mason | 1 | 1 | 0 | |||||||||||||||||
| Penicillium spp. | 1 | 1 | 3 | 1 | 1 | 5 | ||||||||||||||
| Didymella pinodella (L.K. Jones) Qian Chen&L.Cai | 1 | 1 | 0 | |||||||||||||||||
| Total | 14 | 20 | 20 | 18 | 21 | 15 | 16 | 23 | 17 | 23 | 22 | 24 | 16 | 15 | 11 | 18 | 42 | 20 | ||
| Total for cultivars | 54 | 54 | 56 | 69 | 42 | 80 | ||||||||||||||
| Total for irrigated/non-irrigated plots | 164 | 191 | ||||||||||||||||||
| Diversity Index | Group of Fungi | Irrigated | Not Irrigated | ||||||||||||||||||
|---|---|---|---|---|---|---|---|---|---|---|---|---|---|---|---|---|---|---|---|---|---|
| Topstar | Waldspindel | Violette de Rennes | ∑ | Top Star | Waldspindel | Violette de Rennes | ∑ | ||||||||||||||
| 150 | 250 | 350 | 150 | 250 | 350 | 150 | 250 | 350 | 150 | 250 | 350 | 150 | 250 | 350 | 150 | 250 | 350 | ||||
| Relative frequency [Rf] | pathogens | 3.94 | 5.63 | 5.07 | 4.51 | 5.63 | 4.23 | 4.23 | 6.48 | 4.51 | 44.2 | 5.63 | 6.2 | 6.48 | 3.94 | 4.23 | 2.82 | 4.79 | 10.4 | 5.63 | 50.1 |
| saprotrophs | 0 | 0 | 0.56 | 0.56 | 0.28 | 0 | 0.28 | 0 | 0.28 | 1.97 | 0.85 | 0 | 0.28 | 0.56 | 0 | 0.28 | 0.28 | 1.41 | 0 | 3.66 | |
| Dominance [Y] | pathogens | 0.16 | 0.32 | 0.26 | 0.2 | 0.32 | 0.18 | 0.18 | 0.42 | 0.2 | 19.6 | 0.32 | 0.38 | 0.42 | 0.16 | 0.18 | 0.08 | 0.23 | 1.09 | 0.32 | 25.1 |
| saprotrophs | 0 | 0 | 0 | 0 | 0 | 0 | 0 | 0 | 0 | 0.04 | 0.01 | 0 | 0 | 0 | 0 | 0 | 0 | 0.02 | 0 | 0.13 | |
| Species richness [S] | pathogens | 5 | 4 | 2 | 3 | 6 | 2 | 4 | 6 | 4 | 9 | 3 | 4 | 3 | 4 | 4 | 3 | 3 | 6 | 4 | 7 |
| saprotrophs | 1 | 1 | 1 | 2 | 1 | 1 | 1 | 1 | 1 | 4 | 1 | 1 | 1 | 1 | 1 | 1 | 1 | 2 | 1 | 3 | |
| Marglef index [D’] | pathogens | 0.68 | 0.51 | 0.17 | 0.34 | 0.85 | 0.17 | 0.51 | 0.85 | 0.51 | 1.36 | 0.34 | 0.51 | 0.34 | 0.51 | 0.51 | 0.34 | 0.34 | 0.85 | 0.51 | 1.02 |
| saprotrophs | 0 | 0 | 0 | 0.17 | 0 | 0 | 0 | 0 | 0 | 0.51 | 0 | 0 | 0 | 0 | 0 | 0 | 0 | 0.17 | 0 | 0.34 | |
| Shannon-Wiener index [H’] | pathogens | 154 | 256 | 355 | 155 | 256 | 354 | 154 | 256 | 355 | 44.2 | 156 | 256 | 356 | 154 | 254 | 353 | 155 | 260 | 356 | 50.1 |
| saprotrophs | 0.16 | 0.32 | 0.82 | 0.77 | 0.6 | 0.18 | 0.46 | 0.42 | 0.49 | 21.6 | 1.17 | 0.38 | 0.7 | 0.72 | 0.18 | 0.36 | 0.51 | 2.51 | 0.32 | 28.9 | |
| Dominance index [λ] | pathogens | 154 | 256 | 356 | 155 | 256 | 354 | 155 | 257 | 355 | 65.8 | 157 | 257 | 357 | 155 | 254 | 353 | 155 | 263 | 356 | 78.9 |
| saprotrophs | 6 | 5 | 3 | 5 | 7 | 3 | 5 | 7 | 5 | 13 | 4.01 | 5 | 4 | 5 | 5 | 4 | 4 | 8.02 | 5 | 10.1 | |
| Fungal Genus/Species | Irrigated | Total | Not Irrigated | Total | ||||||||||||||||
|---|---|---|---|---|---|---|---|---|---|---|---|---|---|---|---|---|---|---|---|---|
| Topstar | Waldspindel | Violette de Rennes | Topstar | Waldspindel | Violette de Rennes | |||||||||||||||
| Number of Fungal Isolates | ||||||||||||||||||||
| 150 * | 250 | 350 | 150 | 250 | 350 | 150 | 250 | 350 | ∑ | 150 | 250 | 350 | 150 | 250 | 350 | 150 | 250 | 350 | ∑ | |
| Alternaria alternata | 7 | 7 | 8 | 3 | 4 | 5 | 2 | 6 | 2 | 44 | 2 | 2 | 5 | 5 | 2 | 1 | 1 | 18 | ||
| Aspergillus spp. | 2 | 1 | 1 | 4 | 1 | 1 | 1 | 1 | 4 | |||||||||||
| Botrytis cinerea | 2 | 1 | 6 | 12 | 1 | 10 | 2 | 34 | 14 | 1 | 20 | 5 | 1 | 11 | 1 | 43 | ||||
| Cladosporium cladosporioides | 5 | 1 | 1 | 1 | 3 | 11 | 2 | 3 | 5 | |||||||||||
| Cylindrocarpon spp. | 5 | 5 | 0 | |||||||||||||||||
| Epicoccum nigrum | 1 | 1 | 1 | 3 | 0 | |||||||||||||||
| Fusarium avenaceum | 5 | 1 | 2 | 3 | 2 | 2 | 1 | 1 | 17 | 1 | 1 | 10 | 2 | 1 | 2 | 18 | ||||
| Fusarium culmorum | 6 | 6 | 0 | |||||||||||||||||
| Fusarium equiseti | 1 | 3 | 2 | 6 | 3 | 3 | ||||||||||||||
| Fusarium oxysporum | 1 | 2 | 1 | 1 | 5 | 1 | 1 | |||||||||||||
| Fusarium tricinctum | 3 | 3 | 0 | |||||||||||||||||
| Fusarium sambucunum | 1 | 2 | 1 | 1 | 5 | 2 | 1 | 3 | ||||||||||||
| Fusarium solani | 1 | 2 | 1 | 4 | 1 | 4 | 3 | 2 | 2 | 20 | 1 | 3 | 2 | 1 | 7 | |||||
| Fusarium sporitrichioides | 2 | 2 | 0 | |||||||||||||||||
| Fusarium spp. | 1 | 1 | 2 | 1 | 1 | 1 | 7 | 4 | 1 | 3 | 1 | 2 | 11 | |||||||
| Mucor spp. | 1 | 2 | 1 | 4 | 4 | 1 | 13 | 1 | 1 | 1 | 2 | 1 | 6 | |||||||
| Penicillium spp. | 25 | 21 | 25 | 24 | 22 | 30 | 22 | 33 | 32 | 234 | 27 | 31 | 35 | 23 | 31 | 18 | 25 | 28 | 22 | 240 |
| Rhizopus nigricans Ehrenb. | ||||||||||||||||||||
| Rhizopus spp. | 11 | 4 | 13 | 4 | 8 | 4 | 6 | 8 | 58 | 11 | 13 | 10 | 13 | 12 | 12 | 10 | 7 | 13 | 101 | |
| Total | 65 | 48 | 50 | 52 | 51 | 53 | 52 | 54 | 52 | 53 | 53 | 54 | 57 | 70 | 44 | 41 | 55 | 42 | ||
| Total for cultivars | 163 | 156 | 158 | 160 | 171 | 138 | ||||||||||||||
| Total for irrigated/non-irrigated plots | 477 | 469 | ||||||||||||||||||
| Diversity Index | Group of Fungi | Irrigated | Not Irrigated | ||||||||||||||||||
|---|---|---|---|---|---|---|---|---|---|---|---|---|---|---|---|---|---|---|---|---|---|
| Topstar | Waldspindel | Violette de Rennes | ∑ | Top Star | Waldspindel | Violette de Rennes | ∑ | ||||||||||||||
| 150 * | 250 | 350 | 150 | 250 | 350 | 150 | 250 | 350 | 150 | 250 | 350 | 150 | 250 | 350 | 150 | 250 | 350 | ||||
| Relative frequency [Rf] | pathogens | 2.960 | 1.903 | 1.268 | 2.008 | 2.114 | 1.903 | 2.114 | 1.163 | 1.163 | 11.95 | 1.480 | 0.740 | 0.529 | 2.114 | 2.854 | 1.374 | 0.423 | 1.797 | 0.634 | 10.99 |
| saprotrophs | 3.911 | 3.700 | 4.017 | 3.488 | 3.277 | 3.700 | 3.383 | 4.545 | 4.334 | 34.36 | 4.123 | 4.863 | 5.180 | 3.911 | 4.545 | 3.277 | 3.911 | 4.017 | 3.805 | 37.63 | |
| Dominance [Y] | pathogens | 0.088 | 0.036 | 0.016 | 0.040 | 0.045 | 0.036 | 0.045 | 0.014 | 0.014 | 1.43 | 0.022 | 0.005 | 0.003 | 0.045 | 0.081 | 0.019 | 0.002 | 0.032 | 0.004 | 1.21 |
| saprotrophs | 0.153 | 0.117 | 0.161 | 0.122 | 0.107 | 0.137 | 0.114 | 0.207 | 0.188 | 11.62 | 0.170 | 0.236 | 0.268 | 0.153 | 0.207 | 0.107 | 0.153 | 0.161 | 0.072 | 6.33 | |
| Species richness [S] | pathogens | 10 | 6 | 4 | 6 | 5 | 8 | 6 | 5 | 7 | 13 | 2 | 3 | 4 | 5 | 4 | 4 | 3 | 5 | 4 | 8 |
| saprotrophs | 3 | 2 | 2 | 4 | 3 | 2 | 4 | 3 | 3 | 4 | 3 | 4 | 4 | 3 | 2 | 3 | 3 | 2 | 3 | 4 | |
| Marglef index [D’] | pathogens | 1.313 | 0.730 | 0.438 | 0.730 | 0.584 | 1.022 | 0.730 | 0.584 | 0.876 | 1.75 | 0.146 | 0.292 | 0.438 | 0.584 | 0.438 | 0.438 | 0.292 | 0.584 | 0.438 | 1.02 |
| saprotrophs | 0.292 | 0.146 | 0.146 | 0.438 | 0.292 | 0.146 | 0.438 | 0.292 | 0.292 | 0.44 | 0.292 | 0.438 | 0.438 | 0.292 | 0.146 | 0.292 | 0.292 | 0.146 | 0.292 | 0.44 | |
| Shannon–Wiener index [H’] | pathogens | 0.164 | 0.105 | 0.068 | 0.112 | 0.106 | 0.112 | 0.112 | 0.067 | 0.074 | 0.65 | 0.062 | 0.043 | 0.035 | 0.109 | 0.126 | 0.076 | 0.028 | 0.092 | 0.041 | 0.42 |
| saprotrophs | 0.155 | 0.135 | 0.155 | 0.150 | 0.135 | 0.140 | 0.148 | 0.175 | 0.162 | 0.65 | 0.161 | 0.185 | 0.198 | 0.157 | 0.167 | 0.138 | 0.157 | 0.159 | 0.154 | 0.67 | |
| Dominance index [λ] | pathogens | 0.004 | 0.003 | 0.002 | 0.002 | 0.004 | 0.002 | 0.003 | 0.001 | 0.001 | 0.05 | 0.004 | 0.001 | 0.000 | 0.004 | 0.007 | 0.002 | 0.000 | 0.003 | 0.000 | 0.04 |
| saprotrophs | 0.012 | 0.008 | 0.013 | 0.010 | 0.009 | 0.013 | 0.009 | 0.015 | 0.015 | 0.16 | 0.013 | 0.016 | 0.017 | 0.012 | 0.016 | 0.009 | 0.012 | 0.013 | 0.011 | 0.18 | |
Publisher’s Note: MDPI stays neutral with regard to jurisdictional claims in published maps and institutional affiliations. |
© 2021 by the authors. Licensee MDPI, Basel, Switzerland. This article is an open access article distributed under the terms and conditions of the Creative Commons Attribution (CC BY) license (http://creativecommons.org/licenses/by/4.0/).
Share and Cite
Bogucka, B.; Pszczółkowska, A.; Okorski, A.; Jankowski, K. The Effects of Potassium Fertilization and Irrigation on the Yield and Health Status of Jerusalem Artichoke (Helianthus tuberosus L.). Agronomy 2021, 11, 234. https://doi.org/10.3390/agronomy11020234
Bogucka B, Pszczółkowska A, Okorski A, Jankowski K. The Effects of Potassium Fertilization and Irrigation on the Yield and Health Status of Jerusalem Artichoke (Helianthus tuberosus L.). Agronomy. 2021; 11(2):234. https://doi.org/10.3390/agronomy11020234
Chicago/Turabian StyleBogucka, Bożena, Agnieszka Pszczółkowska, Adam Okorski, and Krzysztof Jankowski. 2021. "The Effects of Potassium Fertilization and Irrigation on the Yield and Health Status of Jerusalem Artichoke (Helianthus tuberosus L.)" Agronomy 11, no. 2: 234. https://doi.org/10.3390/agronomy11020234
APA StyleBogucka, B., Pszczółkowska, A., Okorski, A., & Jankowski, K. (2021). The Effects of Potassium Fertilization and Irrigation on the Yield and Health Status of Jerusalem Artichoke (Helianthus tuberosus L.). Agronomy, 11(2), 234. https://doi.org/10.3390/agronomy11020234

